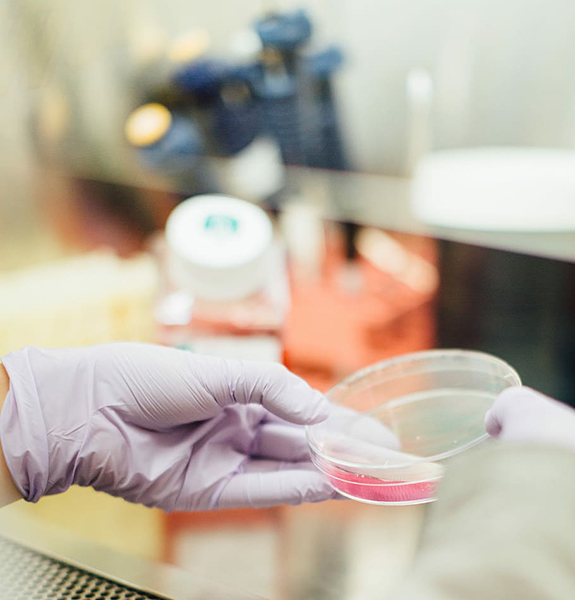

Check Up Base
il Check Up Base comprende tutte le seguenti analisi:
- glicemia
- azotemia
- creatinemia
- uricemia
- emocromo completo
- sideremia
- transaminasi got
- transaminasi gpt
- gamma gt
- colesterolo totale
- colesterolo hdl
- colesterolo ldl
- trigliceridemia
- bilirubina totale
Prova il nostro miglior pacchetto come rapporto qualità-prezzo! Il nostro pacchetto base, disponibile a soli € 22,00 consente di prenotare un Check-Up in grado di fornire informazioni importanti per il tuo medico ed il tuo stato di salute. Questo pacchetto prevedere l’analisi della funzionalità metabolica, renale ed epatica, oltre a molti altri esami inclusi in questa offerta.
Analisi Cliniche Leonardo offre questo pacchetto base presso il laboratorio senza alcun obbligo di prenotazione e soprattutto senza prescrizione medica.
A questo pacchetto potrai aggiungere tutti gli esami che desidererai usufruendo anche di uno speciale sconto dal prezzo di listino.
Altre Offerte
Check Up Base
Pacchetto Uomo
Pacchetto Donna
Profilo Anemia
Profilo Cardiologico
Profilo Tiroideo di Base
Profilo Tiroideo Completo
Profilo MTS (malattie trasmettibili sessualmente)
Profilo Fertilità
Screening Infanzia
Celiachia
Pacchetto Gravidanza 1
Pacchetto Gravidanza 2
Test Allergie
Pacchetto Coagulazione Base
Pacchetto Coagulazione Completo
Screening Diabete
Check Up Pillola Anticoncezionale

Check Up Base a soli 22,00€
ottieni maggiori informazioni

Pacchetto Uomo a soli 50,00€
ottieni maggiori informazioni

Pacchetto Donna a soli 50,00€
ottieni maggiori informazioni

Profilo Anemia a soli 38,00€
ottieni maggiori informazioni

Profilo Cardiologico a soli 55,00€
ottieni maggiori informazioni

Profilo Tiroideo di Base a soli 22,00€
ottieni maggiori informazioni

Profilo Tiroideo Completo a soli 38,00€
ottieni maggiori informazioni

Profilo MTS (malattie trasmettibili sessualmente) a soli 45,00€
ottieni maggiori informazioni
Profilo Fertilità a soli 34,00€
ottieni maggiori informazioni

Screening Infanzia a soli 28,00€
ottieni maggiori informazioni

Celiachia a soli 78,00€
ottieni maggiori informazioni

Pacchetto Gravidanza 1 a soli 48,00€
ottieni maggiori informazioni

Pacchetto Gravidanza 2 a soli 75,00€
ottieni maggiori informazioni

Test Allergie a soli 49,00€
ottieni maggiori informazioni

Pacchetto Coagulazione Base a soli 12,00€
ottieni maggiori informazioni

Pacchetto Coagulazione Completo a soli 19,00€
ottieni maggiori informazioni




